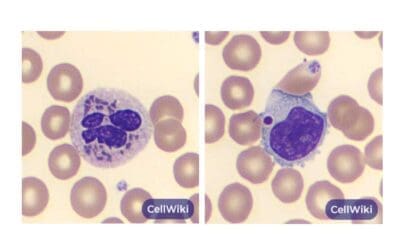
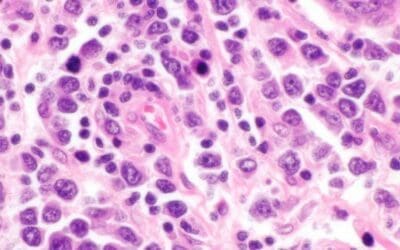

TL;DR
Hairy cell leukemia (HCL) is a rare chronic B-cell leukemia with characteristic “hairy” cells.
- Epidemiology ▾: Primarily affects middle-aged men, with an unknown cause.
- Pathogenesis ▾: Involves abnormal B-cell development and the BRAF V600E mutation.
- Clinical Features ▾: Fatigue, weakness, infections, splenomegaly, and hepatomegaly.
- Laboratory Findings ▾: Pancytopenia, hairy cells on blood smear, bone marrow infiltration, and characteristic flow cytometry markers.
- Differential Diagnosis ▾: Important to distinguish from other leukemias, lymphomas, and myeloproliferative neoplasms.
- Treatment ▾: Historically splenectomy, now primarily chemotherapy (purine analogs), targeted therapy (BRAF inhibitors), and supportive care.
- Prognosis ▾: Generally good with long-term survival rates high due to effective treatments.
HCL-V is a variant with different clinical and genetic features, requiring specific treatment approaches.
*Click on ▾ for more information
Introduction
Hairy cell leukemia (HCL) is a rare chronic B-cell lymphoproliferative disorder characterized by the accumulation of mature B lymphocytes with characteristic “hairy” cytoplasmic projections in the bone marrow, spleen, and liver. These abnormal cells infiltrate the bone marrow, leading to pancytopenia (a decrease in all types of blood cells).
Historical Perspective
- 1923: First described by Paul Schilling, a German hematologist, who noted the presence of atypical cells in the blood of a patient with splenomegaly.
- 1958: Further characterized by Dameshek and Rappaport, who coined the term “hairy cell leukemia.”
- 1970s: Identification of the characteristic immunophenotype of hairy cells, leading to improved diagnosis.
- 1980s: Introduction of interferon-alpha as effective treatment, transforming hairy cell leukemia (HCL) from a fatal to a chronic disease.
- Recent decades: Discovery of the BRAF V600E mutation and development of targeted therapies, further improving outcomes for patients.
Hairy cell leukemia (HCL) was once considered a fatal disease with a poor prognosis. However, advances in understanding the disease and the development of new treatments have significantly improved patient outcomes, transforming it into a chronic, manageable condition for many patients.
Epidemiology
Hairy cell leukemia (HCL) is a relatively uncommon leukemia. The exact incidence and prevalence rates vary across different populations and geographical regions. However, it is estimated that HCL accounts for less than 2% of all adult leukemias.
Age, Gender, and Geographic Distribution
- Age: Hairy cell leukemia (HCL) typically affects middle-aged adults, with the peak incidence occurring in the sixth and seventh decades of life.
- Gender: Hairy cell leukemia (HCL) is more common in men than in women at 4:1 ratio.
- Geographic distribution: While hairy cell leukemia (HCL) occurs worldwide, there may be variations in incidence rates among different populations due to factors such as genetic susceptibility and environmental exposures.
Pathogenesis
B cells are a type of white blood cell crucial for the immune system. They develop in the bone marrow and mature in the lymphoid tissues. Normal B cells differentiate into antibody-producing plasma cells, which are essential for fighting infections.
Transformation into a Hairy Cell
The exact mechanism of transformation of a normal B cell into a hairy cell is not fully understood. However, several key factors are involved:
- BRAF V600E mutation: This genetic alteration is found in almost all cases of hairy cell leukemia (HCL). It leads to the constitutive activation of the MAPK signaling pathway, promoting cell proliferation, survival, and inhibition of apoptosis.
- Other genetic abnormalities: While the BRAF mutation is central, additional genetic changes may contribute to the development and progression of hairy cell leukemia (HCL).
- Microenvironment: The bone marrow microenvironment may play a role in supporting the growth and survival of hairy cells.
Role of BRAF V600E Mutation
The BRAF V600E mutation is a key driver of hairy cell leukemia (HCL) pathogenesis. This mutation results in the constant activation of the MAPK signaling pathway, which is involved in cell growth, proliferation, and survival. The constitutive activation of this pathway leads to uncontrolled growth and survival of hairy cells.
Mechanisms of Bone Marrow Suppression and Cytopenias
Hairy cells infiltrate the bone marrow, displacing normal hematopoietic cells. This infiltration leads to:
- Bone marrow fibrosis: The excessive accumulation of hairy cells can lead to fibrosis (scarring) of the bone marrow, further impairing its function.
- Suppression of hematopoiesis: The infiltration of hairy cells disrupts the normal microenvironment required for the production of red blood cells, white blood cells, and platelets.
- Increased cell destruction: Hairy cells may also contribute to the destruction of normal blood cells.
These factors collectively result in pancytopenia, a condition characterized by a decrease in all types of blood cells.
Clinical Features of Hairy Cell Leukemia (HCL)
Classic Presentation
The classic presentation of hairy cell leukemia (HCL) is often insidious and non-specific. Patients commonly experience:
- Fatigue: Due to anemia caused by decreased red blood cell production.
- Weakness: Related to overall bone marrow suppression and pancytopenia.
- Infections: Recurrent infections occur due to low white blood cell count (neutropenia).
Splenomegaly and Hepatomegaly
- Splenomegaly: Enlargement of the spleen is a hallmark of hairy cell leukemia (HCL), resulting from the accumulation of hairy cells within the organ.
- Hepatomegaly: Enlargement of the liver can also occur, although it is less common than splenomegaly.
Laboratory Investigations for Hairy Cell Leukemia (HCL)

Complete Blood Count (CBC)
A complete blood count (CBC) is a routine blood test that measures the number and types of blood cells, including red blood cells, white blood cells, and platelets. In patients with hairy cell leukemia (HCL), CBC typically reveals:
- Pancytopenia: This refers to a decrease in all three major blood cell lines: red blood cells (anemia), white blood cells (leukopenia), and platelets (thrombocytopenia).
- Monocytopenia: Monocytes are often significantly reduced in hairy cell leukemia (HCL).
Peripheral Blood Smear
In hairy cell leukemia (HCL), the smear may show:
- Hairy cells: These are mature lymphocytes with characteristic hair-like projections on their cell surface, a distinctive feature of hairy cell leukemia (HCL).
- Pancytopenia: The reduced number of red blood cells, white blood cells, and platelets can be directly visualized on the smear, confirming the CBC findings.
Bone Marrow Biopsy
Bone marrow aspiration and biopsy are essential for confirming the diagnosis.
- Infiltration by hairy cells: The bone marrow appears packed with hairy cells.
Flow Cytometry Immunophenotyping
Flow cytometry is used to identify specific markers on the surface of cells. Hairy cells typically positive for CD19, CD20, CD22, CD11c, CD25, CD103, and FMC7
Other Relevant Laboratory Tests
In addition to the tests mentioned above, other laboratory tests may be performed to assess overall health and identify potential complications of HCL. These may include:
- Liver function tests: To evaluate liver function as some patients may have hepatomegaly.
- Coagulation studies: To assess blood clotting function, as thrombocytopenia can increase the risk of bleeding.
- Lactate dehydrogenase (LDH): Often elevated in hairy cell leukemia (HCL) due to increased cell turnover.

Differential Diagnosis of Hairy Cell Leukemia (HCL)
Differentiating HCL from other hematological malignancies can be challenging, as there may be overlapping clinical and laboratory features. It is crucial to consider the following conditions in the differential diagnosis:
Myeloproliferative Neoplasms
- Primary myelofibrosis: Characterized by bone marrow fibrosis, splenomegaly, and cytopenias. However, it typically lacks the characteristic hairy cells and immunophenotype of hairy cell leukemia (HCL).
- Chronic myelogenous leukemia (CML): Usually presents with leukocytosis, blast cells, and the Philadelphia chromosome, which are absent in hairy cell leukemia (HCL).
- Polycythemia vera: Primarily affects red blood cell production, with increased hemoglobin and hematocrit levels.
Other Leukemias
- Chronic lymphocytic leukemia (CLL): Often presents with lymphocytosis and a different immunophenotype compared to hairy cell leukemia (HCL). CLL has a characteristic immunophenotype, expressing CD5, CD19, dim CD20, dim CD22, CD23, bright CD43, dim CD45, dim to negative CD79b, dim CD81, CD200, and dim monoclonal surface immunoglobulin.
- Acute leukemias: Characterized by rapid onset, bone marrow infiltration by immature blast cells, and severe cytopenias.
- Multiple myeloma: Primarily involves bone marrow plasma cell infiltration, leading to lytic bone lesions and hypercalcemia.
Lymphomas
- Splenic marginal zone lymphoma: Can mimic hairy cell leukemia (HCL) with splenomegaly and cytopenias. However, it typically lacks the characteristic hairy cells and immunophenotype. Typical SMZL immunophenotype includes Immunoglobulin−/+, B cell antigen+, CD5−, CD10−, CD23−, CD43−/+, CD11c+/−.
- Mantle cell lymphoma: Usually presents with lymphadenopathy and a different immunophenotype with expression of CD5, CD20 (bright), CD22, FMC-7, CD38, and lambda light chain with no expression of CD23
- Follicular lymphoma: Typically involves lymph node enlargement and has a distinct immunophenotype. The typical immunophenotype of FL as identified by flow cytometry is CD19+ (dim), CD20+ (bright), CD10+ (uniform), CD5–, CD23–, CD200–, CD11c–, with surface expression of restricted immunoglobulin κ-chain or immunoglobulin λ-chain.
Other Considerations
- Aplastic anemia: Characterized by pancytopenia without evidence of malignant cells.
- Myelodysplastic syndromes: A group of disorders characterized by ineffective hematopoiesis and cytopenias.
It is essential to combine clinical presentation, laboratory findings, bone marrow biopsy, and flow cytometry immunophenotyping to accurately differentiate HCL from these other conditions. In some cases, additional diagnostic tests, such as genetic studies or imaging studies, may be necessary.
Treatment and Management
The treatment of hairy cell leukemia (HCL) has evolved significantly in recent years with the advent of targeted therapies. The goal of treatment is to induce remission, improve quality of life, and prolong survival.
General Treatment Principles
- Individualized treatment plans based on patient factors (age, comorbidities, disease stage)
- Management of cytopenias through transfusions or growth factors
- Prophylactic antibiotics to prevent infections
- Regular monitoring of blood counts, liver function, and spleen size
Treatment Options
- Splenectomy
- Historically, splenectomy was a cornerstone of treatment, but its role has diminished with the availability of effective medical therapies. It may still be considered in patients with symptomatic splenomegaly or refractory cytopenias.
- Chemotherapy
- Purine analogs (pentostatin, cladribine): Highly effective in inducing remission.
- Interferon-alpha: Can be used as first-line or maintenance therapy, especially in younger patients.
- Targeted therapy
- BRAF inhibitors: Due to the frequent presence of the BRAF V600E mutation in HCL, targeted therapy with BRAF inhibitors has emerged as a promising treatment option. Drugs like vemurafenib and encorafenib have shown efficacy in inducing deep remissions.
- Supportive care
- Blood transfusions for anemia
- Platelet transfusions for thrombocytopenia
- Granulocyte colony-stimulating factor (G-CSF) for neutropenia
- Antibiotic prophylaxis
Monitoring and Follow-up
Regular follow-up is essential to assess treatment response, monitor for disease recurrence, and manage potential complications. This typically involves:
- Complete blood count (CBC)
- Liver function tests
- Splenic assessment
- Bone marrow biopsy (periodically)
Prognosis
The prognosis for patients with HCL has significantly improved due to advancements in treatment. Overall, the outlook for patients with HCL is good. Long-term survival is common and many patients can live normal lives with effective treatment.
Factors Affecting Prognosis
While the overall prognosis is favorable, several factors can influence individual outcomes:
- Stage of disease at diagnosis: Early detection and treatment often lead to better outcomes.
- Patient’s overall health and age: Younger patients with good overall health tend to have better prognoses.
- Response to treatment: Patients who achieve complete remission and maintain long-term disease control have a better outlook.
- Presence of complications: Infections or other health problems can impact prognosis.
Survival Rates
- 5-year survival rate: Approximately 95%
- 10-year survival rate: Approximately 87%
Hairy Cell Leukemia Variant (HCL-V)
Hairy cell leukemia variant (HCL-V) was once considered a rare subtype of hairy cell leukemia (HCL), but it is now recognized as a distinct entity with different clinical, laboratory, and genetic characteristics.
Key Differences Between HCL and HCL-V
| Feature | Classic HCL | HCL-V |
| Genetics | BRAF V600E mutation | MAP2K1 mutation |
| Bone marrow | Dry tap, fibrosis | Aspirable, hypercellular |
| Blood count | Pancytopenia, monocytopenia | Normal or increased white blood cell count |
| Spleen | Enlarged | Enlarged |
| Treatment | Purine analogs, splenectomy, targeted therapy (BRAF inhibitors) | Rituximab, chemotherapy |
Clinical Features of HCL-V
Patients with hairy cell leukemia variant (HCL-V) often present with:
- Splenomegaly
- Fatigue
- Abdominal fullness or pain
- Increased risk of infections
Unlike classic hairy cell leukemia (HCL), patients with HCL-V typically do not have pancytopenia or monocytopenia.
Diagnosis of HCL-V
The diagnosis of HCL-V is based on:
- Clinical presentation
- Blood tests: Normal or increased white blood cell count
- Bone marrow biopsy: Aspirable, hypercellular with infiltration of hairy cells
- Flow cytometry: Similar immunophenotype to classic hairy cell leukemia (HCL) but with distinct genetic markers
- Genetic testing: Identification of the MAP2K1 mutation
Treatment of HCL-V
Treatment for HCL-V differs from classic hairy cell leukemia (HCL). Current treatment options include:
- Rituximab: A monoclonal antibody targeting CD20
- Chemotherapy: Drugs such as chlorambucil or fludarabine
- Splenectomy: May be considered in selected cases
While HCL-V is less common than classic hairy cell leukemia (HCL), it is important to recognize the distinct features of this disease to ensure appropriate diagnosis and treatment.
Frequently Asked Questions (FAQs)
What are the stages of hairy cell leukemia?
Hairy cell leukemia (HCL) does not have a formal staging system. However, it is often classified based on the extent of disease involvement and the severity of symptoms.
Here’s a general classification based on clinical features:
- Early-stage: Characterized by fatigue, weakness, and splenomegaly. Blood counts may show pancytopenia.
- Intermediate-stage: More pronounced symptoms, including infections and bone pain. Splenomegaly is often significant.
- Advanced-stage: Severe symptoms, such as jaundice, bleeding, and organ failure. Bone marrow involvement may be extensive.
It’s important to note that this classification is not a strict staging system but rather a general guide to help assess the severity of the disease. Treatment decisions are often based on the individual patient’s symptoms, laboratory findings, and overall health.
Can hairy cell leukemia spread to other organs?
Yes, hairy cell leukemia (HCL) can spread to other organs. While the spleen is the most commonly affected organ, HCL can also involve the liver, bone marrow, and lymph nodes. In rare cases, the disease may spread to other organs, such as the lungs or skin.
It’s important to note that the spread of HCL to other organs is often associated with advanced stages of the disease and can lead to more severe symptoms and complications. However, with effective treatment, the progression of HCL can be managed, and the spread of the disease can be limited.
Who is at risk for hairy cell leukemia?
Identifying specific risk factors for hairy cell leukemia (HCL) is challenging. While the exact cause remains unknown, certain factors may increase the risk:
- Age: The incidence of HCL increases with age, with the peak occurring in the sixth and seventh decades of life.
- Gender: HCL is more common in men than in women.
- Genetic predisposition: While specific genetic mutations have been identified, such as the BRAF V600E mutation, the overall genetic risk for HCL is not fully understood.
- Environmental factors: Some studies suggest that exposure to certain environmental factors may be associated with an increased risk of HCL, but these associations are not definitive.
It’s important to note that these are potential risk factors, and not everyone with these characteristics will develop HCL.
What is the confirmatory test for hairy cell leukemia?
Bone marrow biopsy is the confirmatory test for hairy cell leukemia (HCL). It involves removing a sample of bone marrow tissue to examine under a microscope. The presence of hairy cells, which are abnormal B cells with characteristic hair-like projections, is a hallmark of HCL.
Additionally, flow cytometry can be used to identify specific markers on the surface of hairy cells, further confirming the diagnosis.
Can you survive hairy cell leukemia?
Yes, it is possible to survive hairy cell leukemia. With advancements in treatment, many people with HCL can live long and productive lives. The prognosis for HCL has significantly improved in recent years, and many patients can achieve long-term remission.
While there is no cure for HCL, the disease is often treatable. Effective treatments can help manage symptoms, improve quality of life, and extend survival.
Remember, the outlook for individuals with HCL varies. Factors such as the stage of the disease, overall health, and response to treatment can influence individual outcomes.
Disclaimer: This article is intended for informational purposes only and is specifically targeted towards medical students. It is not intended to be a substitute for informed professional medical advice, diagnosis, or treatment. While the information presented here is derived from credible medical sources and is believed to be accurate and up-to-date, it is not guaranteed to be complete or error-free. See additional information.
References
- Naing PT, Acharya U, Kumar A. Hairy Cell Leukemia. [Updated 2023 May 22]. In: StatPearls [Internet]. Treasure Island (FL): StatPearls Publishing; 2024 Jan-. Available from: https://www.ncbi.nlm.nih.gov/books/NBK499845/
- Roider T, Falini B, Dietrich S. Recent advances in understanding and managing hairy cell leukemia. F1000Res. 2018 Apr 27;7:F1000 Faculty Rev-509. doi: 10.12688/f1000research.13265.1. PMID: 29770206; PMCID: PMC5931274.
- Ahmadzadeh A, Shahrabi S, Jaseb K, Norozi F, Shahjahani M, Vosoughi T, Hajizamani S, Saki N. BRAF Mutation in Hairy Cell Leukemia. Oncol Rev. 2014 Sep 23;8(2):253. doi: 10.4081/oncol.2014.253. PMID: 25992240; PMCID: PMC4419648.
- Pagano L, Criscuolo M, Broccoli A, Piciocchi A, Varettoni M, Galli E, Anastasia A, Cantonetti M, Trentin L, Kovalchuk S, Orsucci L, Frustaci A, Spolzino A, Volpetti S, Annibali O, Storti S, Stelitano C, Marchesi F, Offidani M, Casadei B, Nizzoli ME, De Luca ML, Fianchi L, Motta M, Guarnera L, Simonetti E, Visentin A, Vassallo F, Deodato M, Sarlo C, Olivieri A, Falini B, Pulsoni A, Tiacci E, Zinzani PL. Long-term follow-up of cladribine treatment in hairy cell leukemia: 30-year experience in a multicentric Italian study. Blood Cancer J. 2022 Jul 19;12(7):109. doi: 10.1038/s41408-022-00702-9. PMID: 35853850; PMCID: PMC9296486.